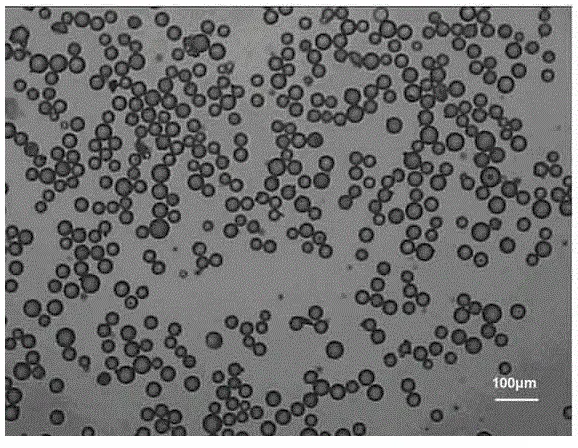

小编今天带大家一起来学习氨基/羧基/醛基/苯肼基/磺酸基/醛基化改性交联修饰聚苯乙烯微球的研究与制备,来看!
磺酸基/醛基化改性交联修饰聚苯乙烯微球的研究:
在缚酸剂Na2CO3存在下,使溶胀的氯甲基化交联聚苯乙烯(CMCPS)微球表面的氯甲基与对羟基苯甲醛(HBA)发生亲核取代反应,制得了醛基(AL)化改性的交联聚苯乙烯(ALCPS)微球;利用所制得的ALCPS微球与甘氨酸(GL)发生缩合反应,制备了同时含有席夫碱配基与羧基的席夫碱型螯合树脂AGCPS微球。采用红外光谱法表征了微球功能基团的结构变化,重点研究了CMCPS微球醛基化改性反应,考察了影响亲核取代反应的主要因素,推测和探讨了反应的机理。研究表明,CMCPS微球表面的苄氯基团与HBA缩合反应的速率与HBA的浓度无关,属于典型的SN1反应;使用极性较强的溶剂DMF,在较高的反应温度(90℃)下,有利于亲核取代反应的进行。所得席夫碱型螯合树脂对铜离子具有较强的螯合吸附能力。
氨基修饰聚苯乙烯微球的制备:
采用分散聚合法以苯乙烯(St)为单体,偶氮二异丁腈(AIBN)为引发剂,聚乙烯吡咯烷酮(PVP)为分散剂,乙醇和水的混合液为分散介质合成了聚苯乙烯微球,再通过硝化反应与还原反应制成了粒径均匀,稳定性好的氨基聚苯乙烯微球.通过扫描电子显微镜,激光粒径分析仪对微球的外观形貌,单分散性分别进行表征,并用电导滴定法测定了微球表面氨基含量.结果表明,所合成的氨基聚苯乙烯微球粒径在2μm左右,具有良好的单分散性且氨基含量较高.
相关内容
氯乙酰化聚苯乙烯微球(PS-acyl-Cl)
表面聚N-乙烯基乙酰胺接枝聚苯乙烯(PNVA-g-PSt)微球
磺化聚苯乙烯/壳聚糖复合微球
氨基化聚苯乙烯(PA)微球
环氧化聚苯乙烯微球
胺化聚苯乙烯微球
含氟双官能团聚苯乙烯微球
环氧基团表面修饰聚苯乙烯微球
羧基官能团化聚苯乙烯微球
二苯甲酮光引发基团聚苯乙烯(PS) 微球
瑞禧YWX.2022.9.1










 本文介绍了磺酸基/醛基化改性交联聚苯乙烯微球及氨基修饰聚苯乙烯微球的制备方法。通过亲核取代反应和缩合反应在聚苯乙烯微球表面引入功能基团,如磺酸基、醛基和氨基,制备了具有席夫碱配基与羧基的螯合树脂以及氨基化的微球。研究表明,反应条件如溶剂类型和温度对功能化反应有显著影响,所得材料对金属离子具有良好的吸附性能。
本文介绍了磺酸基/醛基化改性交联聚苯乙烯微球及氨基修饰聚苯乙烯微球的制备方法。通过亲核取代反应和缩合反应在聚苯乙烯微球表面引入功能基团,如磺酸基、醛基和氨基,制备了具有席夫碱配基与羧基的螯合树脂以及氨基化的微球。研究表明,反应条件如溶剂类型和温度对功能化反应有显著影响,所得材料对金属离子具有良好的吸附性能。
















 355
355

 被折叠的 条评论
为什么被折叠?
被折叠的 条评论
为什么被折叠?








